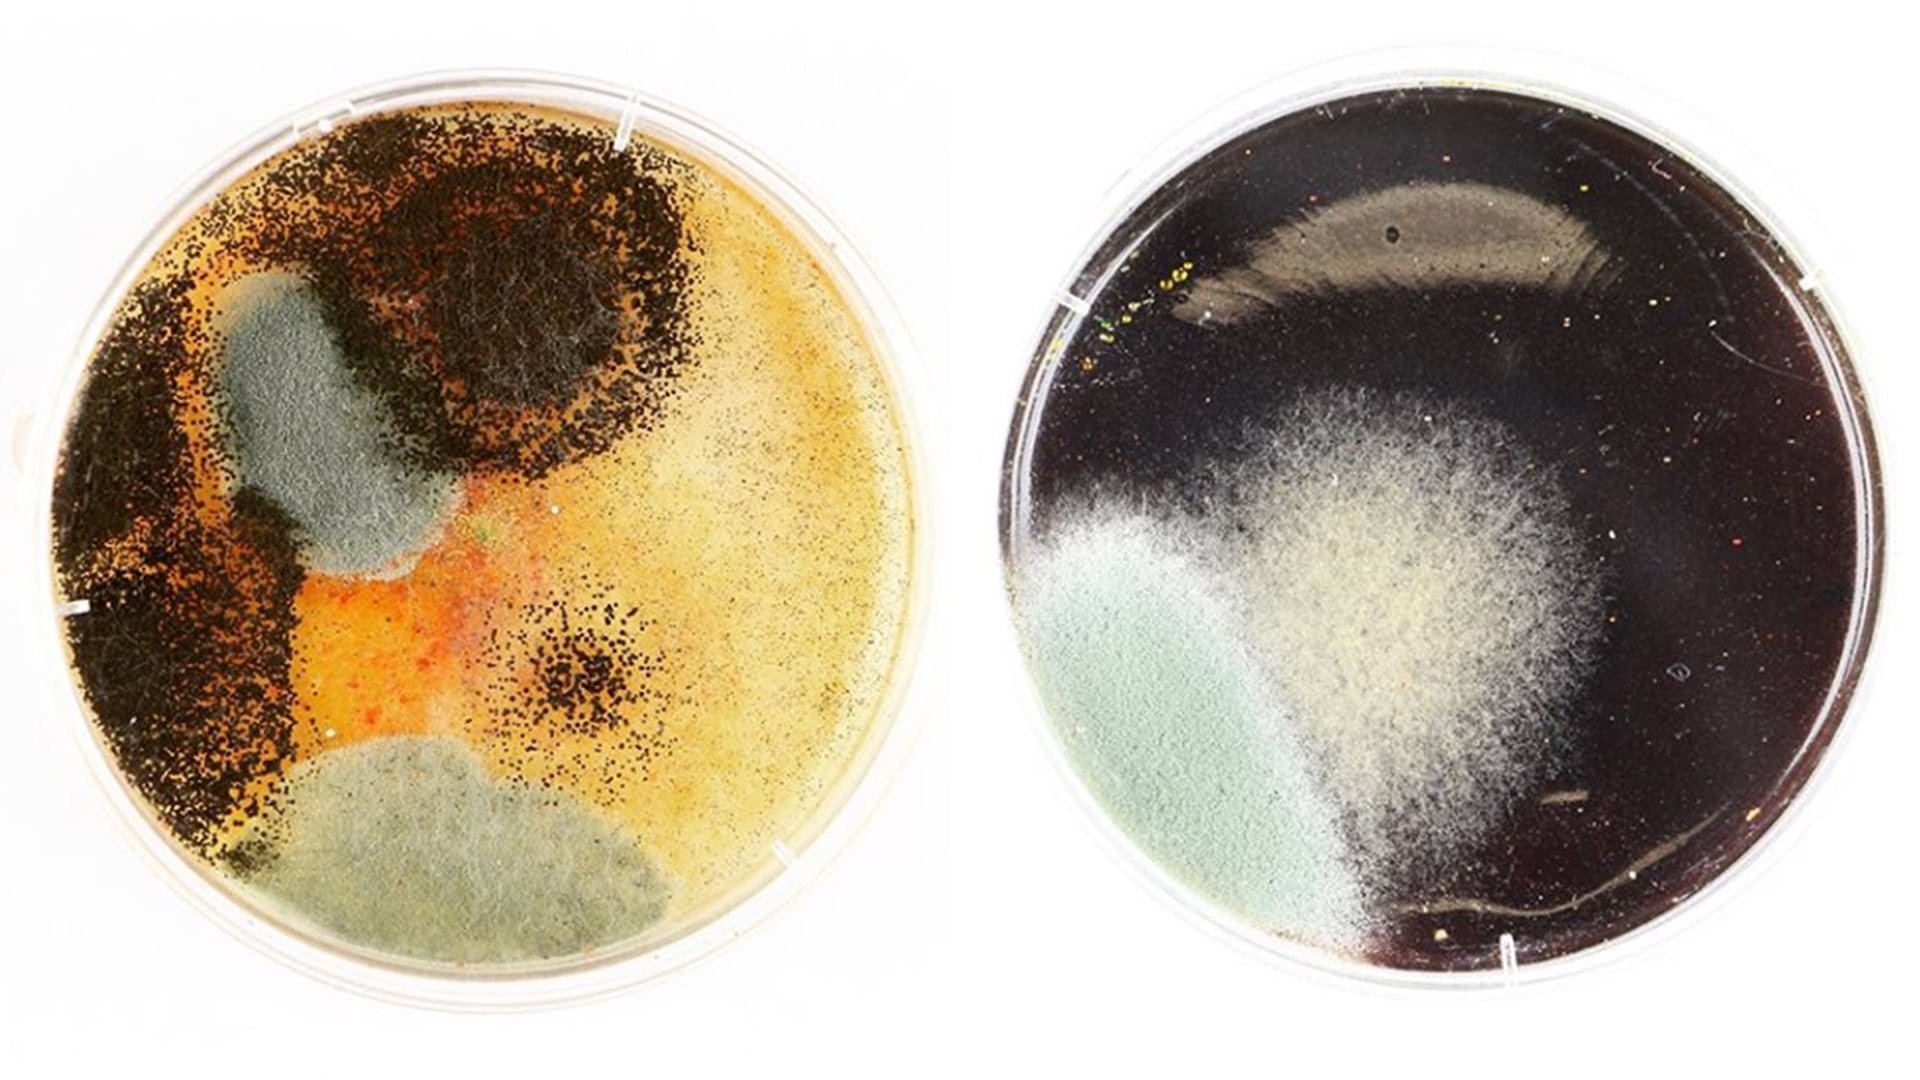

About
Art and science are often seen as two different entities with very separate ideas of what constitutes research. Increasingly, collaborations between artists and scientists are a feature of our cultural landscape. A hybrid form of research has emerged over the last 30 years where artists and scientists are interested in the creative possibilities and speculative futures of the intersection of these two cultures.
The MA Art in Science programme at Liverpool School of Art and Design, Liverpool John Moores University, brings artists and scientists together to collaborate across disciplines. The programme cultivates specialist, transferable skills directed towards future vocational opportunities; and facilitates transdisciplinary learning opportunities that are not often available to those singly defined as ‘artists’, ‘scientists’ or ‘researchers’.